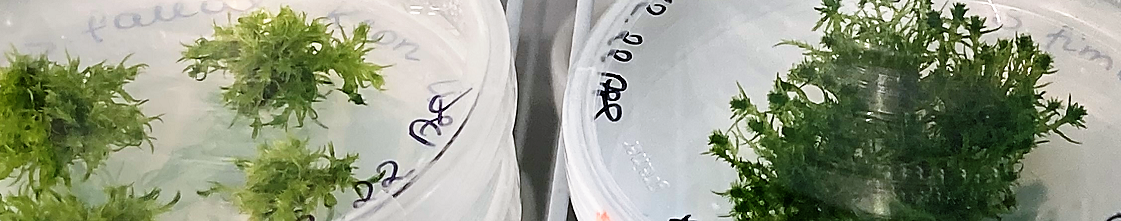
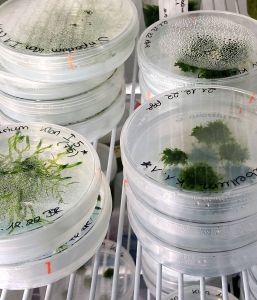

MOOSstart
Verbundvorhaben „Ertragssteigerung und Hochskalieren der Produktion und Ausbringung von Saatgut als Initiale für den Anbau nachwachsender Torfmoos-Biomasse in Paludikultur“.

Das Projekt MOOSstart stellt sich drei Herausforderungen unserer Zeit und möchte damit beitragen, die Ziele des Pariser Klimaschutzabkommens von 2015 zu erreichen: Es gilt die CO2-Emissionen aus drainierten Moorböden durch Wiedervernässung möglichst auf null zu reduzieren, das Verwenden von fossilem Torf im Gartenbau zu beenden und gleichzeitig Alternativen für Landnutzung und Erwerbsgartenbau sicherzustellen.
Der Torfmoos-Anbau in Paludikultur bietet die einzigartige Möglichkeit, hochwertige nachwachsende Substratrohstoffe für den Erwerbsgartenbau auf wiedervernässten abgetorften und degradierten Hochmooren zu produzieren - mit Gewinn für Klima und Biodiversität. Das haben das Vorgängerprojekt MOOSzucht sowie die Forschungsprojekte MOOSGRÜN, MOOSWEIT oder OptiMOOS gezeigt.
Für ein Skalieren der Torfmoos-Paludikultur fokussiert das Projekt MOOSstart auf den ersten Teil der Produktionskette: die Herstellung großer Mengen an Saatgut für die Einrichtung neuer Flächen. Im Vorgängerprojekt MOOSzucht ist es gelungen, vegetatives Ausgangsmaterial in einem Photobioreaktor axenisch zu vermehren. Schwerpunkt in MOOSstart ist es, dieses Verfahren weiterzuentwickeln und einen low cost-Bioreaktor zu konstruieren, damit es großmaßstäbiger, kostengünstiger und möglichst dezentral anwendbar ist. Geplant ist auch ein Testlauf für einen ersten low cost-Bioreaktor, der bei einem potentiellen Anwender aufgestellt werden soll. Für das produzierte Saatgut untersucht MOOSstart die Anpassung bzw. Entwicklung geeigneter Technik zur Aussaat auf wiedervernässten Hochmoorböden. MOOSstart arbeitet zudem an der Erhöhung der Ernteerträge – ein entscheidender Faktor für die Rentabilität von Torfmoos-Paludikultur.
Die Projekt-Ergebnisse sollen zur Transformation hin zu einer klimaneutralen Moornutzung und Substratwirtschaft beitragen und so die Vorreiterrolle Deutschlands hinsichtlich Torfmoos-Paludikultur und der nachhaltigen Produktion von nachwachsenden Substratausgangsstoffen stärken.
Anzucht von Torfmoosen und Vermehrung im Photobioreaktor (Fotos: N. Körner)
Arbeitsschwerpunkte
Das Verbundprojekt MOOSstart beinhaltet:
- Produktivitätssteigerung bei Torfmoosen auf molekularer (UF und HSA) und Provenienzen-/Art-Ebene (UG, Aufträge)
- Entwicklung eines low cost-Bioreaktors zum Hochskalieren der Massenvermehrung von vegetativem Torfmoos-Ausgangsmaterial (HSA) sowie Testlauf bei einem potentiellen Anwender (NIRA)
- Ökonomie der Saatgutherstellung im low cost-Bioreaktor (HSA)
- Entwicklung einer angepassten Technik für die Ausbringung von im low cost-Bioreaktor produzierten Torfmoos-Saatgut (NIRA)
- Koordination und Öffentlichkeitsarbeit (UG)

Verbundpartner:innen
- Universität Greifswald, Inst. für Botanik und Landschaftsökologie (UG), Partner im Greifswald Moor Centrum (GMC), AG Moorforschung
- Universität Freiburg (UF), Institut für Biologie II Arbeitsgruppe: Pflanzenbiotechnologie
- Hochschule Anhalt, Fachbereich Angewandte Biowissenschaften und Prozesstechnik (HSA)
- Niedersächsische Rasenkulturen, NIRA GmbH & Co. KG (NIRA)
Interner Bereich
Login für Projekt-Partner:innen